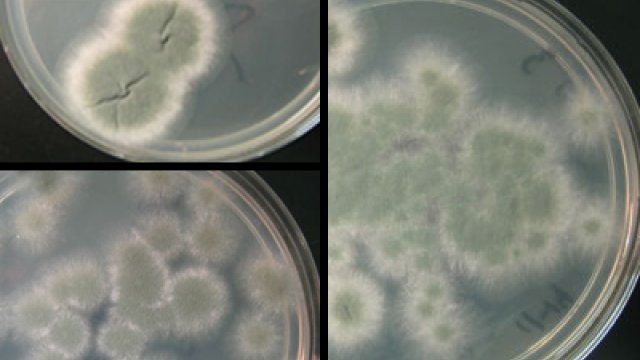

Mold Information Slideshow
Learn the Facts!
-

Mold Basics
The key to mold control is moisture control. If mold is a problem in your home, you should clean up the mold promptly and fix the water problem.
It is important to dry water-damaged areas and items within 24-48 hours to prevent mold growth.
Molds gradually destroy the things they grow on. You can prevent damage to your home and furnishings, save money, and avoid potential health problems by controlling moisture and eliminating mold growth. -

Molds are Part of the Natural Environment
Outdoors, molds play a part in nature by breaking down dead organic matter, such as fallen leaves and dead trees, but indoors, mold growth should be avoided.
Molds reproduce by means of tiny spores; the spores are invisible to the naked eye and float through outdoor and indoor air.
Mold may begin growing indoors when mold spores land on surfaces that are wet. There are many types of mold, and none of them will grow without water or moisture.
-

Can Mold Cause Health Problems?
Molds are usually not a problem indoors, unless mold spores land on a wet or damp spot and begin growing.
Molds have the potential to cause health problems.
Inhaling or touching mold or mold spores may cause allergic reactions in sensitive individuals.
Molds can also cause asthma attacks in people with asthma who are allergic to mold. In addition, mold exposure can irritate the eyes, skin, nose, throat and lungs of both mold-allergic and non-allergic people.
For health concerns, consult a health professional or your state or local health department.
-

How Do I Get Rid of Mold?
It is impossible to get rid of all mold and mold spores indoors. Mold spores will not grow if moisture is not present. Indoor mold growth can and should be prevented or controlled by controlling moisture indoors.
If there is mold growth in your home, you must clean up the mold and fix the water problem. If you clean up the mold, but don't fix the water problem, then, most likely, the mold problem will come back.
-

Mold Cleanup
Who should do the cleanup depends on a number of things.
One consideration is the size of the mold problem.
If the moldy area is less than about 10 square feet (less than roughly a 3 ft. by 3 ft. patch), in most cases, you can handle the job yourself following EPA's mold guidelines. If you have health concerns, consult a health professional before starting cleanup.
If there has been a lot of water damage and/or mold growth covers more than 10 square feet, you may choose to hire a contractor (or other professional service provider) to do the cleanup.
If the water and/or mold damage was caused by sewage or other contaminated water, then call in a professional who has experience cleaning and fixing buildings damaged by contaminated water.
-

Mold Cleanup Guidelines
Fix plumbing leaks and other water problems as soon as possible. Dry all items completely.
Scrub mold off hard surfaces with detergent and water, and dry completely.
Absorbent or porous materials, such as ceiling tiles and carpet, may have to be thrown away if they become moldy.
Avoid exposing yourself or others to mold (see discussions: What to Wear When Cleaning Moldy Areas and Hidden Mold).
Do not paint or caulk moldy surfaces. Clean up the mold and dry the surfaces before painting. Paint applied over moldy surfaces is likely to peel. -

What to Wear When Cleaning Moldy Areas
Moisture Control is the Key to Mold Control.
Wear an N-95 respirator to avoid breathing in mold or mold spores. N-95 respirators may be found in many hardware stores and from companies that advertise on the Internet. In order to be effective, the respirator or mask must fit properly, so carefully follow the instructions supplied with the respirator.
Wear gloves to avoid touching mold or moldy items with your bare hands. Long gloves that extend to the middle of the forearm are recommended. To learn about what types of gloves to wear, see Cleanup and Biocides.
Wear goggles to avoid getting mold or mold spores in your eyes. Goggles that do not have ventilation holes are recommended. -

How Do I Know When the Remediation or Cleanup is Finished?
You must have completely fixed the water or moisture problem before the cleanup or remediation can be considered finished.
You should have completed mold removal. Visible mold and moldy odors should not be present. Please note that mold may cause staining and cosmetic damage.
You should have revisited the site(s) shortly after cleanup, and it should show no signs of water damage or mold growth.
People should have been able to occupy or re-occupy the area without health complaints or physical symptoms.
Ultimately, this is a judgment call; there is no easy answer. -

Moisture and Mold Prevention and Control Tips
When water leaks or spills occur indoors — ACT QUICKLY. If wet or damp materials or areas are dried 24-48 hours after a leak or spill happens, in most cases mold will not grow.
Clean and repair roof gutters regularly.
Make sure the ground slopes away from the building foundation, so that water does not enter or collect around the foundation.
Keep air conditioning drip pans clean and the drain lines unobstructed and flowing properly.
Keep indoor humidity below 60 percent (ideally between 30 and 50 percent).
If you see condensation or moisture collecting on windows, walls or pipes ACT QUICKLY to dry the wet surface and reduce the moisture/water source. Condensation can be a sign of high humidity.
Learn more about actions that will help to actions to reduce humidity and help prevent condensation. -
Testing or Sampling for Mold
Is sampling for mold needed?
In most cases, if visible mold growth is present, sampling is unnecessary.
Since no EPA or other federal limits have been set for mold or mold spores, sampling cannot be used to check a building's compliance with federal mold standards.
Surface sampling may be useful to determine if an area has been adequately cleaned or remediated.
Sampling for mold should be conducted by professionals who have specific experience in designing mold sampling protocols, sampling methods and interpreting results. Sample analysis should follow analytical methods recommended by the American Industrial Hygiene Association (AIHA), the American Conference of Governmental Industrial Hygienists (ACGIH) or other professional organizations.
-

Hidden Mold
You may suspect hidden mold if a building smells moldy, but you cannot see the source, or if you know there has been water damage and residents are reporting health problems.
Mold may be hidden in places such as:The back side of dry wall, wallpaper, or paneling
The top side of ceiling tiles
The underside of carpets and pads
Inside walls around pipes
The surface of walls behind furniture
Inside ductwork
In roof materials above ceiling tiles (due to roof leaks or insufficient insulation)If you believe that you may have a hidden mold problem, consider hiring an experienced professional.
-

Cleanup and Biocides
Biocides are substances that can destroy living organisms.
The use of a chemical or biocide that kills organisms such as mold (chlorine bleach, for example) is not recommended as a routine practice during mold cleanup. If you choose to use disinfectants or biocides, always ventilate the area and exhaust the air to the outdoors.
In most cases, it is not possible or desirable to sterilize an area; a background level of mold spores will remain — these spores will not grow if the moisture problem has been resolved.
There may be instances, however, when professional judgment may indicate use of a chemical or biocide (for example, when immune-compromised individuals are present).
Never mix chlorine bleach solution with other cleaning solutions or detergents that contain ammonia because toxic fumes could be produced.
-

More Information
A Brief Guide to Mold, Moisture, and Your Home
This Guide provides information and guidance for homeowners and renters on how to clean up residential mold problems and how to prevent mold growth.
To view or download EPA's complete guidance please go to A Brief Guide to Mold, Moisture and Your Home
